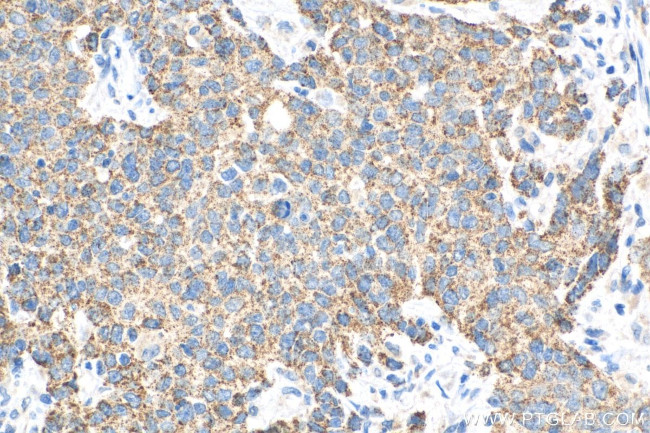
FBXW11 Antibody in Immunohistochemistry (Paraffin) (IHC (P))

Search
Proteintech
FBXW11 Monoclonal Antibody (1F5A10)
{{$productOrderCtrl.translations['antibody.pdp.commerceCard.promotion.promotions']}}
{{$productOrderCtrl.translations['antibody.pdp.commerceCard.promotion.viewpromo']}}
{{$productOrderCtrl.translations['antibody.pdp.commerceCard.promotion.promocode']}}: {{promo.promoCode}} {{promo.promoTitle}} {{promo.promoDescription}}. {{$productOrderCtrl.translations['antibody.pdp.commerceCard.promotion.learnmore']}}
产品信息
68090-1-IG150UL
种属反应
宿主/亚型
分类
类型
克隆号
偶联物
形式
浓度
规格
纯化类型
保存液
内含物
保存条件
运输条件
靶标信息
This gene encodes a member of the F-box protein family which is characterized by an approximately 40 amino acid motif, the F-box. The F-box proteins constitute one of the four subunits of ubiquitin protein ligase complex called SCFs (SKP1-cullin-F-box), which function in phosphorylation-dependent ubiquitination. The F-box proteins are divided into 3 classes: Fbws containing WD-40 domains, Fbls containing leucine-rich repeats, and Fbxs containing either different protein-protein interaction modules or no recognizable motifs. The protein encoded by this gene belongs to the Fbws class and, in addition to an F-box, contains multiple WD40 repeats. This gene contains at least 14 exons, and its alternative splicing generates 3 transcript variants diverging at the presence/absence of two alternate exons.
仅用于科研。不用于诊断过程。未经明确授权不得转售。
篇参考文献 (0)
生物信息学
蛋白别名: beta-transducin repeat-containing protein 2; F-box and WD repeats protein beta-TrCP2; F-box and WD-40 domain protein 11; F-box and WD-40 domain protein 1B; F-box protein Fbw1b; F-box/WD repeat-containing protein 11; F-box/WD repeat-containing protein 1B; Homologous to Slimb protein; HOS; unnamed protein product
基因别名: 2310065A07Rik; AA536858; BTRC2; BTRCP2; Fbw11; FBW1B; FBXW11; FBXW1B; HOS; KIAA0696; NEDJED
UniProt ID: (Human) Q9UKB1, (Mouse) Q5SRY7
Entrez Gene ID: (Human) 23291, (Mouse) 103583, (Rat) 303024